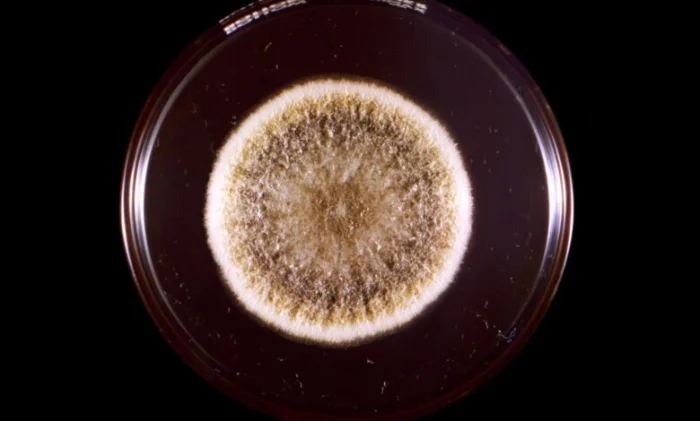
Токсичный грибок из древних гробниц может помочь в борьбе с лейкемией

Токсичный грибок из древних гробниц может помочь в борьбе с лейкемией
Исследователи обнаружили, что молекулы, выделенные из токсичного грибка Aspergillus flavus, который часто встречается в древних захоронениях, обладают мощным противораковым действием. В ходе экспериментов с клетками лейкемии эти соединения показали эффективность, сопоставимую с препаратами, одобренными Управлением по санитарному надзору за качеством пищевых продуктов и медикаментов США (FDA). Результаты исследования открывают новые перспективы в разработке противораковых лекарств на основе грибковых соединений.
Aspergillus flavus — это токсичная плесень с желтыми спорами, известная своей опасностью для здоровья. Она выделяет токсины, способные вызывать смертельные легочные инфекции, особенно у людей с ослабленным иммунитетом или хроническими заболеваниями. Грибок распространен повсеместно: его можно найти в почве, разлагающейся органике, подвалах, гробницах, а также в плохо хранящихся зерновых и сухофруктах.
Известность Aspergillus flavus приобрел после загадочных смертей нескольких археологов, участвовавших в раскопках гробницы Тутанхамона в 1920-х годах. Это породило слухи о «проклятии фараона», однако позже врачи предположили, что причиной гибели людей стала инфекция, вызванная спорами грибка, которые сохранялись в гробнице тысячелетиями.
Кроме того, A. flavus мог быть связан со смертями 10 из 12 ученых, исследовавших гробницу польского короля Казимира IV в 1970-х годах. Последующие анализы подтвердили наличие большого количества спор этого грибка в захоронении.
Несмотря на свою опасность, некоторые грибы обладают ценными лекарственными свойствами. В новом исследовании, опубликованном в журнале Nature Chemical Biology, ученые из Университета Пенсильвании показали, что A. flavus может стать неожиданным источником противораковых соединений.
«Грибы подарили нам пенициллин», — говорит Шерри Гао, доцент Университета Пенсильвании и ведущий автор исследования. «Наши результаты показывают, что в природных соединениях еще много неизученного потенциала для создания лекарств».
Многообещающее действие против лейкемии
Исследователи выделили из грибка особый класс пептидов — рибосомально синтезируемые и посттрансляционно модифицированные пептиды (RiPP). Их обнаружение представляет сложность, поскольку RiPP грибкового происхождения часто путают с нерибосомными пептидами. Если тысячи бактериальных RiPP уже известны, то у грибов их найдено лишь несколько.
Команда Гао проанализировала 12 штаммов Aspergillus, чтобы выявить наиболее перспективные RiPP. Оказалось, что соединения, производимые A. flavus, обладают высокой биологической активностью. Эти пептиды кодируются специфическим белком, и его отключение полностью прекращало их выработку.
Ученые выделили четыре RiPP из A. flavus и обнаружили, что они имеют необычную структуру из вложенных колец. Новые молекулы, названные «асперигимицинами», продемонстрировали значительную противораковую активность. Два из них особенно эффективно подавляли клетки лейкемии.
Дальнейшие исследования показали, что асперигимицины нарушают процесс деления клеток, блокируя образование микротрубочек. Это объясняет их противораковое действие, так как раковые клетки характеризуются бесконтрольным размножением.
Эффективность на уровне одобренных препаратов
В другом эксперименте ученые добавили к RiPP липид — компонент маточного молочка, питательного вещества, которое пчелы производят для кормления личинок и матки. В результате комбинация показала эффективность, сравнимую с цитарабином и даунорубицином — препаратами, десятилетиями используемыми для лечения лейкемии.
Липиды помогли новым соединениям проникать в клетки. Чтобы понять механизм этого эффекта, исследователи избирательно активировали и деактивировали гены в раковых клетках. Оказалось, что ген SLC46A3 играет ключевую роль, регулируя проникновение асперигимицинов в клетки через лизосомы.
«Этот ген действует как шлюз», — объясняет Цююэ Ни, соавтор исследования. «Он не только облегчает попадание асперигимицина в клетки, но и может помочь другим циклическим пептидам, которые обычно требуют модификации для эффективного проникновения».
При этом асперигимицины почти не воздействовали на клетки рака груди, печени и легких, а также на бактерии и другие грибы. Это указывает на их избирательное действие.
Кроме того, ученые обнаружили схожие гены у других грибов, что говорит о возможном существовании неизученных RiPP с терапевтическим потенциалом. Следующим шагом станет тестирование асперигимицинов на животных моделях, а в случае успеха — клинические испытания.




















































